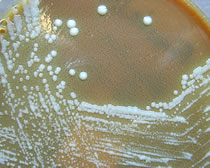

|
◆岸波通信その193 黎明期の群像/野兎病と大原八郎 ※写真は野兎病の病原体↑ |
The History of modern medicine in Fukushima3 2022.3.22配信
ふくしま近代医学150年~黎明期の群像シリーズ・コラム
|
 |
大原八郎 (葵会仙台病院顧問大原義郎氏提供) |
彼は新たな病気を疑い研究を開始した。八郎は、大原病院の創立者・大原一の娘婿だ。
◆真っ向から対立
野兎病(やとびょう)は北緯30度以北の北半球に広く分布しており、特に北米のものは強毒種で重篤化する危険性が高い。未治療の場合、致死率は30~60%。
また野兎病に関する世界最古の症例記録は1837(天保8)年、華岡青洲(はなおかせいしゅう)門下で水戸藩侍医を務めた本間棗軒(そうけん)が『瘍科秘録』に記した「食兎中毒」とされる。残念ながらその後、歴史に埋もれた。
 |
本間棗軒 |
さて、八郎が研究を始めた頃、宮城県でも同様な患者が東北帝国大学付属病院の杉村外科に来訪し研究が開始された。
八郎による野兎病の究明は大学のチームと先陣争いの様相を呈する。
翌1925年3月12日、八郎が『実験医報』に論文を発表すると、わずか2日後、東北帝国大学のチームが『東京医事新誌』で発表。
八郎が論文を発表した時代の『実験医報』
辛うじて野兎病発見の栄誉は八郎の手になったが、そこで新たな問題が発生する。
両者は同じ疾患を対象としているにもかかわらず、その原因について八郎は細菌説を、東北帝国大学チームはスピロヘータあるいはウイルス説を唱え真っ向から対立したのだ。
明らかにするには病原体を突き止めるしかない。八郎は人体実験を志向する。だがリスクの高い実験の被験者がそうそう見つかるはずもない。
最終的に、当時40歳だった彼の妻りきが自ら志願し、八郎はこれを受け入れる。
 |
大原八郎、りき夫妻 医学書院『臨床検査』第65巻第2号 |
彼の娘婿である仏文学者中島健蔵は、この時の心境について後に義父からこう打ち明けられている。
「実験が成功するかどうか確率は半分半分だろう。冷静に考えれば矛盾だらけだが心の中でむしろ実験が失敗すればいいという気持ちになってきた」と。
天に祈る気持ちであったに違いない。
りきの献身により実験は成功し、抽出された病原体は協力者の名と合わせて「大原=芳賀球菌」と命名された。2人の共著論文が発表された同年9月26日が野兎病の原因菌確定の日だ。
なお論文にはリンパ腺が腫脹した、りきの無着衣の上半身写真が掲載され、摘出手術は原因菌に影響を及ぼすことを避けるため麻酔なしで行われた。夫婦の覚悟が伝わるエピソードではないか。
その頃米国で、全く別個に野兎病の研究が行われていた。
エドワード・フランシスの論文「ツラレミア」に触れた八郎は、それが野兎病と同じ病気ではないかと考え、研究記録を彼に送る。
 |
エドワード・フランシス 【米国公衆衛生局医療局長】 |
フランシスは八郎の協力を得ながら苦心の末、同一疾患の証明に成功し、1926年5月、学術誌『JAMA』で発表した。2人の執念が生んだ偉業だ。
学術誌『JAMA』
なお、フランシスの論文の直前に掲載されていたのはスピロヘータに関する野口英世の論文だった。全くの偶然だが、福島県出身の2人の医師が関わった重要な発表が同時になされたのだ。
◆強い感染力特徴
わが国で野兎病は古くて新しい病気と言われる。近年発生数が減少し、2008(平成20)年の5例、15年の福島県の1例を最後に報告はない。
他方で野兎病菌は極めて感染力が強く、皮膚の創傷部だけでなく健康な皮膚からも侵入できる特異な菌であることから、バイオテロの兵器とされることが懸念されている。
米国では炭疽(たんそ)菌、エボラウイルスなどと同じ危険度Aに分類される。存在が再注目されているのだ。
野兎病が発症した患部(Wikipedia)
現在、日本での発症はほとんどないが、北欧やロシアでは年間100例以上の患者が発生しており、感染者が入国してくることも考えられる。
医療人にとって忘れてならない疾患であることは間違いないだろう。
(福島県立医大医学部同窓会特任事務局長 岸波靖彦)
◆京都帝大在学中に結婚 (福島民友新聞社による補稿)
大原病院第2代院長の大原八郎(1882~1943年)は、阿部平次郎の四男として伊達郡長岡村(現伊達市長岡)に生まれた。
旧家の出で、桑折町の小学校(現醸芳小)から旧制の安積中に進み、仙台の東北学院普通科1年を経て第二高校、京都帝国大学医学部で学んだ。『大原病院史』によると、小学校の頃から医師を目指した。
りきは大原一の一人娘で、東京女子高等師範学校(現お茶の水女子大)を卒業している。
八郎との交際は、八郎の二高時代から始まり、京都帝大在学中に結婚したことなどを、長男で第3代院長の甞一郎が病院史に綴(つづ)っている。
文字通り、最愛の2人だったことは他の資料からもうかがえる。
 |
現在の大原綜合病院 (提供:大原記念財団) |
京都帝大で医学部助手を経験し福島に戻った八郎は、大原病院副院長に就任。1917(大正6)年から22年までは東北帝国大学医学部に出向して助手、助教授を務め、外科や耳鼻咽喉科の臨床技術を高めた。
22年に再び大原病院副院長に就き、1年余りして野兎病の研究を始めることになる。
病原の解明に懸ける八郎の熱意と、りきの献身。報道を受け国内外から、りきへの称賛が寄せられる一方、八郎には事情を解さない批判があったことも病院史は伝える。
りきは大きな併発症もなく治癒し、八郎の論文やフランシスとの研究につながっていった。
/// end of the “その193「黎明期の群像/野兎病と大原八郎」” ///
 |
《追伸》
「ふくしま近代医学150年/黎明期の群像」は2022年3月21日掲載の野口英世編をもってシリーズ完了となります。
ただこの後、関係者による座談会が4月上旬に開催され、その模様がインタビュー記事として連休前か連休中あたりに掲載予定となっています。
ボランティアで執筆にご協力をいただいた皆さま、取材にご協力いただいた皆さま、大変ありがとうございました。
なお、シリーズの書籍化については、現在、共同企画者である福島県立医大医学部同窓会と福島民友新聞社とで検討中です。
もし、書籍として購入したいという方がございましたら、福島民友新聞社へご要望下さいませ。
では、また次の通信で・・・See you again !
 |
福島県立医科大学の歴史 (英語版及び日本語・増補改訂版) |
管理人「葉羽」宛のメールは habane8@ybb.ne.jp まで!


Give the author your feedback, your comments + thoughts are always greatly appreciated.
To be continued⇒“194”coming soon!
【岸波通信その193「黎明期の群像~野兎病と大原八郎」】2022.3.22配信 |
